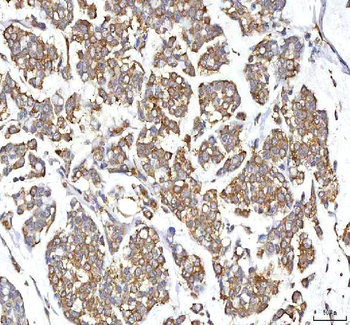
GOLGA7 Rabbit Polyclonal Antibody

You have no items in your shopping cart.
All Products
- LDAH Rabbit Polyclonal Antibody [orb1804698]
ELISA, FC, IHC, WB
Human, Monkey, Mouse, Rat
Rabbit
Polyclonal
Unconjugated
100 μg - Grp75 Mouse Monoclonal Antibody [orb865658]
FC, ICC, IF, IHC, WB
Human, Mouse, Rat
Mouse
Monoclonal
Unconjugated
100 μg - Glutaminase/GLS Mouse Monoclonal Antibody [orb865660]
ICC, IF, IHC, WB
Human, Mouse, Rat
Mouse
Monoclonal
Unconjugated
100 μg - Neurofibromin/NF1 Mouse Monoclonal Antibody [orb865676]
FC, IHC, WB
Human, Mouse, Rat
Mouse
Monoclonal
Unconjugated
100 μg - Neurofibromin/NF1 Mouse Monoclonal Antibody [orb865677]
FC, ICC, IF, IHC, WB
Human, Mouse, Rat
Mouse
Monoclonal
Unconjugated
100 μg - Moesin/MSN Mouse Monoclonal Antibody [orb865589]
FC, ICC, IF, IHC, WB
Human, Monkey, Mouse, Rat
Mouse
Monoclonal
Unconjugated
100 μg - Cytokeratin 5 Mouse Monoclonal Antibody [orb865590]
FC, ICC, IF, IHC, WB
Human
Mouse
Monoclonal
Unconjugated
100 μg - Acid phosphatase/ACP5 Rabbit Polyclonal Antibody [orb865599]
ELISA, FC, ICC, IF, IHC, WB
Human, Mouse, Rat
Rabbit
Polyclonal
Unconjugated
100 μg